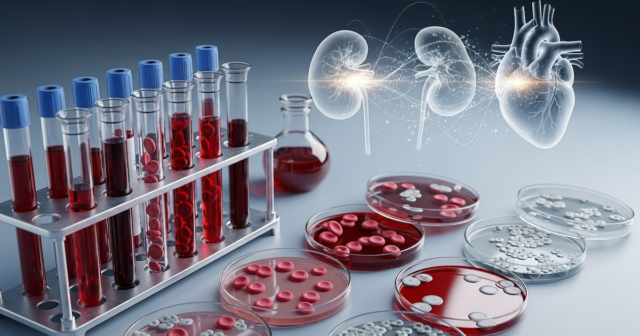

Avanços recentes mostram que uma biomarcadores sanguíneos básicos Alzheimer Também pode ser usado para diagnosticar doenças cardíacas e renais. amiloidose.
Pesquisador de Centro Alemão de Doenças Neurodegenerativas (DZNE) e o Instituto Hertie de Pesquisa Clínica do Cérebro, com uma equipe da Alemanha, Itália e Holanda, confirmaram que a proteína tau fosforilada, usada para diagnosticar a doença de Alzheimer, também está aumentada em pessoas com doenças cardíacas e amiloidose renal. Remédios naturais sim Medicina natural.
Novas evidências revelam que um aumento da tau fosforilada no sangue, considerado exclusivo da doença de Alzheimer, ocorre em duas formas comuns de amiloidose sistêmica: transtirretina e amiloidose de cadeia leve de imunoglobulina.
A pesquisa amplia o campo dos biomarcadores, que podem detectar doenças cardíacas e renais relacionadas aos depósitos de amiloide por meio de exames de sangue, que podem substituir procedimentos médicos como biópsias.

A pesquisa examinou uma amostra de 280 idosos da sede na Europa. Os resultados mostraram que o nível de tau fosforilada foi maior em pacientes com amiloidose sistêmica, mesmo após ajuste para variáveis como idade, sexo e função renal.
Este aumento não se limita à doença de Alzheimer e reflecte a acumulação de proteínas anormais em órgãos como o coração e os rins. Isto é o que o autor diz Medicina naturalque detalha que a tau também é expressa fora do cérebro, incluindo nervos periféricos e tecido cardíaco.

De acordo com DIAO acúmulo de amilóide pode causar estresse celular que estimula a liberação de tau fosforilada no sangue. Estudos em animais e humanos sustentam que esta resposta ocorre em vários órgãos, não apenas no sistema nervoso central.
Estudos demonstraram que níveis elevados de tau fosforilada ocorrem em diferentes condições de amiloidose cardíaca e renal. Analisando todos os grupos, os pesquisadores descobriram que os resultados permaneceram fortes após ajustes para idade, sexo e função renal, confirmando o valor dos biomarcadores na identificação de processos amilóides fora do cérebro, de acordo com o estudo. Medicina natural.
Os especialistas DIA Explique que a proteína tau não é exclusiva do sistema nervoso central e a sua expressão em células e órgãos periféricos como o miocárdio e o rim pode confirmar a sua presença aumentada face ao dano amilóide.
Embora os especialistas estejam cientes da possibilidade de biomarcadores no diagnóstico precoce, alertam sobre Restrição de tau fosforilada para diagnóstico específico da doença de Alzheimer. “O nível de pTau no sangue não é um marcador específico, portanto dados adicionais devem ser considerados ao diagnosticar a doença de Alzheimer ou avaliar a sua progressão”, disse Mathias Jucker do The DIAnos depoimentos coletados Medicina natural.
Recomenda-se que esta análise seja integrada num painel mais amplo de ensaio de biomarcador. Uma interpretação isolada pode levar a um erro diagnóstico, especialmente em idosos ou naqueles que apresentam sintomas de polineuropatia.
A equipa de investigação destaca que, embora a quantidade de tau fosforilada aumente nas fases iniciais da doença de Alzheimer, este padrão pode ser observado na amiloidose sistémica. Portanto, a avaliação clínica deve correlacionar esses resultados com outros exames para evitar erros diagnósticos.
Além disso, os biomarcadores são importantes para distinguir entre polineuropatia relacionada à amiloidose – uma condição que causa dormência e formigamento nas extremidades – que tem outras causas. De acordo com Medicina naturalApenas os casos de polineuropatia derivada da amiloidose apresentam elevação da tau fosforilada, um recurso útil para o diagnóstico diferencial.

Estudos mostram que A identificação de tau fosforilada no sangue pode acelerar o diagnóstico de amiloidose cardíaca e renal e polineuropatia secundária a essas doenças. Até agora, a confirmação destas condições exigia métodos invasivos como biópsias ou cintilografia óssea, especialmente para a variante transtirretina, segundo informações publicadas no Medicina natural.
O ensaio multicêntrico produziu números notáveis: uma área sob o 0,82com um Sensibilidade de 75% e um 80% pessoal discriminar entre amiloidose e controles, de acordo com os dados aí publicados Medicina natural. Esta demonstração foi confirmada em diferentes grupos europeus, que apoiam a possível utilização de biomarcadores sanguíneos na detecção de amiloidose sistémica antes do aparecimento de sintomas graves.
Os pesquisadores sugeriram que melhorias futuras nos imunoensaios permitiriam a diferenciação entre variantes periféricas e cerebrais da tau, aumentando a especificidade diagnóstica na diferenciação entre Alzheimer e doença cardíaca ou amiloidose renal.
A utilização da tau fosforilada como marcador comum da doença de Alzheimer e da amiloidose facilitará o diagnóstico precoce e ajudará a confirmar e evitar casos suspeitos nos casos em que não existem outros testes clínicos.
Esses avanços mudam a interpretação do biomarcador tau fosforilado, que mostra que seu aumento não é apenas Alzheimer, mas também indica a presença de doença amilóide fora do cérebro. As descobertas convidam o pessoal clínico a adotar uma abordagem mais holística à avaliação diagnóstica e oferecem novos caminhos para diagnosticar e tratar estas doenças.